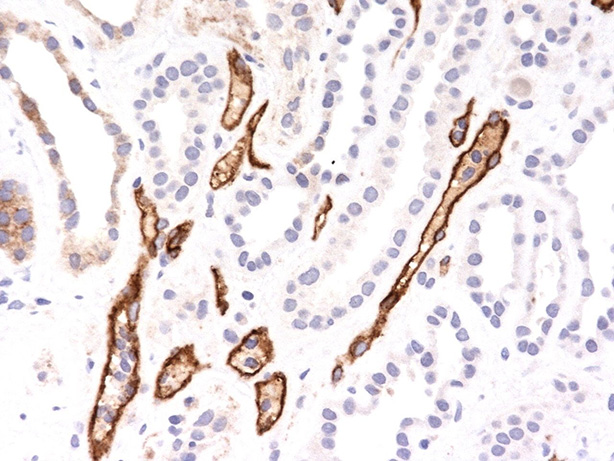

> Antigen, Antibodies, ELISA, Western Blot > Primary Antibody > Monoclonal Antibodies > Complement 4d (C4d) (Acute Humoral Rejection Marker) Antibody - With BSA and AzideBrand |
Leading Biology | Catalog Number |
AMM00081G |
Product Type |
Monoclonal Antibodies | Field of Research |
|
Product Overview |
We constantly strive to ensure we provide our customers with the best antibodies. As a result of this work we offer this antibody in purified format.
We are in the process of updating our datasheets. If you have any questions regarding this update, please feel free to contact our technical support team.
This product is a high quality Complement 4d (C4d) (Acute Humoral Rejection Marker) Antibody - With BSA and Azide.
|
||
Molecular Weight |
192kDa (predicted)
|
||
Cellular Localization |
Antigen Cellular Localization:
Secreted.
|
||
Host |
Mouse
|
||
Species Reactivity |
Human
|
||
Target |
Recombinant human Complement 4d protein
|
||
Clone |
C4D204
|
||
Isotype |
IgG1, kappa
|
||
Symbol |
CO4, CPAMD2
|
||
GeneID |
|||
UniProt ID |
|||
Function |
Non-enzymatic component of C3 and C5 convertases and thus essential for the propagation of the classical complement pathway. Covalently binds to immunoglobulins and immune complexes and enhances the solubilization of immune aggregates and the clearance of IC through CR1 on erythrocytes. C4A isotype is responsible for effective binding to form amide bonds with immune aggregates or protein antigens, while C4B isotype catalyzes the transacylation of the thioester carbonyl group to form ester bonds with carbohydrate antigens.
|
||
Summary |
This MAb is specific to Complement 4d (C4d) and it reacts with the secreted as well as cell-bound C4d. C4d is a degradation product of the activated complement factor C4b. Complement 4b is typically activated by binding of Abs to specific target molecules. Following activation and degradation of the C4 molecule, thio-ester groups are exposed, which allow transient, covalent binding of the degradation product Complement 4d to endothelial cell surfaces and extracellular matrix components of vascular basement membranes near the sites of C4 activation. The presence of C4d in peritubular capillaries is a key indicator for acute humoral (i.e. antibody-mediated) rejection of kidney, heart, pancreas and lung allografts. As an established marker of antibody-mediated acute renal allograft rejection and its proclivity for endothelium, this component can be detected in peritubular capillaries in chronic renal allograft rejection as well as hyperacute rejection, acute vascular rejection, acute cellular rejection, and borderline rejection. It has been shown to be a significant predictor of transplant kidney graft survival. Anti-C4d, combined with anti-C3d, can be utilized as a tool for diagnosis of allograft rejection that may warrant a prompt and aggressive anti-rejection treatment.
|
||
Form |
Liquid. Purified antibody supplied in 1x PBS buffer with 0.09% (w/v) sodium azide and 2% sucrose. |
||
Storage & Stability |
Store at +4°C short term. For long-term storage, aliquot and store at -20°C or below. Stable for 12 months at -20°C. Avoid repeated freeze-thaw cycles.
|
||
Applications |
IHC, IF
|
||
Images |

Formalin-fixed, paraffin-embedded human kidney transplant tissue (10X) stained with Complement 4d MAb (C4D204). 
Formalin-fixed, paraffin-embedded human kidney transplant tissue (20X) stained with Complement 4d MAb (C4D204).
Formalin-fixed, paraffin-embedded human kidney transplant tissue (40X) stained with Complement 4d Ab (C4D204). |
||
Specification |
|||
Quantity |
|
||
| Select | Brand | Catalog No. | Product Name | Pack Size | Type | Field of Research | Specification | Quantity | Price(USD) | |
| 1 | Leading Biology | APG02467G | CCK4 / PTK7 Antibody (clone 4F9) | 50 μl | Monoclonal Antibodies |
|
$495.00 | Add Ask | ||
| 2 | Leading Biology | AMM04683G | GALT Antibody (clone 4C11) | 50 μg | Monoclonal Antibodies |
|
$545.00 | Add Ask | ||
| 3 | Leading Biology | AMM01402G | Vimentin (Mesenchymal Cell Marker) Antibody - With BSA and Azide | 50 ug | Monoclonal Antibodies |
|
$395.00 | Add Ask | ||
| 4 | Leading Biology | APR08280G | LTA4H / LTA4 Antibody (clone 9G8) | 50 μl | Monoclonal Antibodies |
|
$495.00 | Add Ask | ||
| 5 | Leading Biology | AMM00172G | CD1a / HTA1 (Mature Langerhans Cells Marker) Antibody - With BSA and Azide | 50 ug | Monoclonal Antibodies |
|
$395.00 | Add Ask | ||
| 6 | Leading Biology | AMM05750G | CEBPA Antibody | 100 μl | Monoclonal Antibodies |
|
$545.00 | Add Ask |
 Leading Biology Inc.
2600 Hilltop DR, Building G, B Suite C138
Richmond, CA, 94806
Tel: 1-661-524(LBI)-0262
Email: info@leadingbiology.com
Leading Biology Inc.
2600 Hilltop DR, Building G, B Suite C138
Richmond, CA, 94806
Tel: 1-661-524(LBI)-0262
Email: info@leadingbiology.com
Complete this form and click send to ask us a question, request a quote or simply say hello.

You have 0 item in your cart

You have 0 item in your inquiry list
